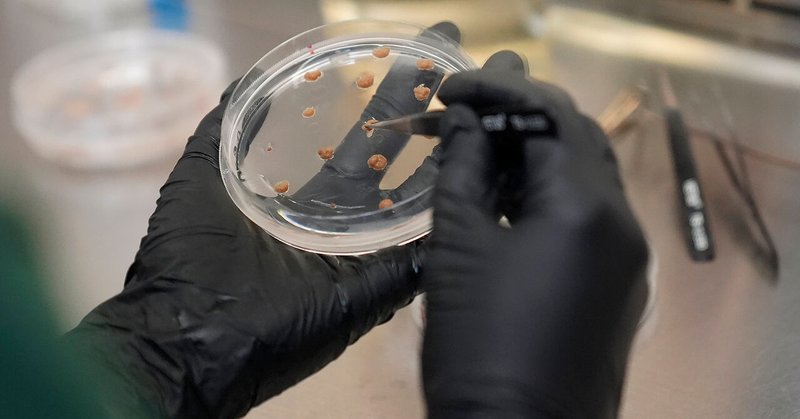
Tweet card summary image

California Cultured
@CaCultured
Followers
615
Following
618
Media
89
Statuses
344
We make sustainable chocolate and coffee from plant cells. 🌱 Not an alternative - the real thing. 🌍 🍫☕️ Cultured chocolate tasting kits coming soon... ⬇
Joined January 2021
Thanks @CGTNAmerica for producing this great explainer video about what we're up to at California Cultured HQ. Take a look at our fantastic science team doing what they do on the daily and learn about our process for making chocolate through plant cell culture. #futureofchocolate
4
4
15
Article by Lebensmittel Zeitung, to read the article please use this link: https://t.co/WdGtxZUQxp
0
0
3
We are very excited to have our VP of Science and Technology, Dr. Steven Lang, speaking at iCAMP (Integrative Center for Alternative Meat & Protein)’s next high-impact networking event, PROTEIN CENTRAL, this Thursday November 20th at UC Davis! https://t.co/Iw3LIkrcpM
0
0
3
New article from @guardian by Adrienne Matei! Check it out using the link below! 🍫
theguardian.com
It could eventually cut down on the production of traditional chocolate, which degrades soil and requires much fertilizer and pesticides
0
0
2
Happy Halloween from all of us at California Cultured! #futureofchocolate #ethicalchocolate #halloweencandy
1
1
3
A big thank you to the team from @Marketplace for taking the time to talk to us about our cell cultured chocolate!! 🍫🧫🎙️ Please check it out - listen here: https://t.co/Bz7MAzZGZC
marketplace.org
The world needs to eat less meat, but can we stomach the alternatives?
0
0
3
We are very excited to have our VP of Science and Technology, Dr. Steven Lang, speaking at @SOToxicology Food Safety Specialty Section on October 29th! Please check it out - registration is free! https://t.co/8jQLvhGUUQ
https://t.co/DCjpGI5adU
toxchange.toxicology.org
Hosted by the SOT Food Safety Specialty Section Registration is required for this free webinar
Delve into the science behind cultivated chocolate, including the cellular agriculture techniques used to produce cocoa without relying on conventional farming, and more during a free #SOTWebinar on October 29. Learn more and register: https://t.co/W6Pioud4sT
0
0
2
We had a great time last week at MISTA's Growth Hack on Healthy Nutrition Demo Day! It was amazing to see all the new innovations and changes in our food system, and we're so glad to have been a part of it! Thank you to everyone who worked so hard to put on this wonderful event.
0
0
2
We can't wait for everyone to demo our healthy and delicious chocolate at MISTA Growth Hack this Wednesday! 🍫
0
0
4
We recently published a groundbreaking patent! It is based on advanced cell cultured cocoa technology that is going to push product quality forward. Here's the article, written by Elaine Watson and published by @agfundernews
https://t.co/7vDeHAneS0
0
3
3
Thank you @annie_crabill from @TheEconomist for taking the time to speak with us about our lab-grown cocoa. Check it out here! 🌱🍫 https://t.co/qQguKCsqko
economist.com
Can science solve the problem of a shortage of beans?
1
5
9
Thank you Mark Anderson from @Sacbiz for taking the time to to talk with about our lab-grown chocolate. Check it out here! 🌱🧫🍫 https://t.co/jGTUxoSgek
bizjournals.com
Even though cacao, the base for chocolate, doesn’t naturally grow in the Sacramento Valley, the region has a deep connection to the tropical fruit as local entrepreneurs and scientists work to keep...
0
3
3
At California Cultured, we are producing real, sustainable cocoa and coffee made from plant cell culture. If you're interested in our journey, press follow! If you interested in supporting in style, please check out our merchandise on our website! Link is in our bio! #chocolate
2
1
6
Thank you Steve Fisher with Lifeslices Podcast for taking the time to chat with us about the future of coffee and chocolate. 🍫☕️ Please check it out here! https://t.co/JwMucUezLh
0
0
2
Big thanks to @Biz4GoodPodcast with @PaulHShapiro for taking the time to talk with us about our cell-grown cocoa! Link to listen is down below! https://t.co/HayuoFA428
businessforgoodpodcast.com
We all know chocolate is sweet. The way that it’s made—not so much. From deforestation and climate change to child labor and heavy metal contamination, cocoa farming leaves a lot to be desired. But...
1
0
4
California Cultured announced a scaling milestone by successfully transitioning from laboratory-scale experiments to large-scale biomanufacturing of cell-based cocoa. @CaCultured
#cellag #futureoffood
https://t.co/aEgzV9A9KH
0
2
10
Great Article from @APNews written by Amy Taxin and Terry Chea! We are always glad to be featured in conversations about producing sustainable chocolate. Read this article through link on this post. A must read! 🍫 https://t.co/9IISmEMyT2
apnews.com
From California to Israel, companies are aiming to grow cocoa beyond the tropics in a bid to buffer chocolate's key ingredient from climate change.
0
0
2
This is the lens we used to back deep tech companies like @colossal (de-extinction), @Cemvita (sustainable oils from waste), @powbio (continuous fermentation), @CaCultured (plant cell fermentation for chocolate and coffee), @AralezBio (non-canonical amino acids synthesis),
0
1
2
MrBeast speaks on the corruption of American Chocolate Companies revealing 46% of cocoa field workers are children… he created “Feastables” to prove there is a more ethical way to do business that doesn’t involve children
157
269
7K
We’re excited to welcome @CaCultured to our community! Their innovative approach to sustainable food production aligns with our vision for a greener, more resilient future. #WestSacramento #SustainableFuture #Innovation
0
2
6
How does this happen? Heavy metals like lead and cadmium accumulate in soil, water, and crops, especially in areas with industrial pollution. Even organic and plant-based sources aren’t immune. Cocoa (used in chocolate flavors) is especially prone to heavy metal contamination.
5
14
199